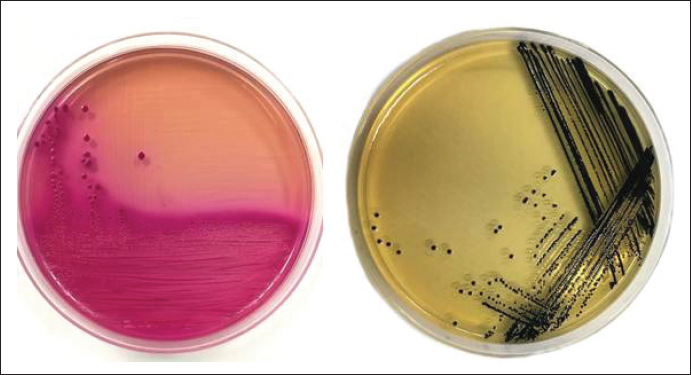

| Research Article | ||
Open Vet. J.. 2025; 15(5): 2160-2170 Open Veterinary Journal, (2025), Vol. 15(5): 2160-2170 Research Article Antibiotic resistance profiles of Escherichia coli and Salmonella spp. isolated from chicken meat sold in traditional markets in Gresik District, East Java, IndonesiaFreshinta Jellia Wibisono1, Mustofa Helmi Effendi2, Wiwiek Tyasningsih3*, Reina Puspita Rahmaniar4, Aswin Rafif Khairullah5, Irfan Alias Kendek1, Budiastuti Budiastuti6, Vinsensius Rianto1, Dicky Candra Nico4, Dea Anita Ariani Kurniasih7, Salsabila Salwa1, Dinda Prisilya Diningrum4, Ikechukwu Benjamin Moses8 and Riza Zainuddin Ahmad51Veterinary Public Health Laboratory, Faculty of Veterinary Medicine, Universitas Wijaya Kusuma Surabaya, Surabaya, Indonesia 2Division of Veterinary Public Health, Faculty of Veterinary Medicine, Universitas Airlangga, Surabaya, Indonesia 3Division of Veterinary Microbiology, Faculty of Veterinary Medicine, Universitas Airlangga, Surabaya, Indonesia 4Veterinary Microbiology Laboratory, Faculty of Veterinary Medicine, Universitas Wijaya Kusuma Surabaya, Surabaya, Indonesia 5Research Center for Veterinary Science, National Research and Innovation Agency (BRIN), Bogor, Indonesia 6Study Program of Pharmacy Science, Faculty of Health Science, Universitas Muhammadiyah Surabaya, Surabaya, Indonesia 7Research Center for Public Health and Nutrition, National Research and Innovation Agency (BRIN), Bogor, Indonesia 8Department of Applied Microbiology, Faculty of Science, Ebonyi State University, Abakaliki, Nigeria *Corresponding Author: Wiwiek Tyasningsih. Division of Veterinary Microbiology, Faculty of Veterinary Medicine, Universitas Airlangga, Surabaya, Indonesia. Email: wiwiek-t [at] fkh.unair.ac.id Submitted: 15/02/2025 Revised: 15/04/2025 Accepted: 21/04/2025 Published: 31/05/2025 © 2025 Open Veterinary Journal
ABSTRACTBackground: Antibiotic resistance in the poultry industry poses a global threat. The occurrence of resistance in humans can occur through foodstuffs of animal origin, one of which is chicken meat, which is sold in traditional markets. Traditional markets are synonymous with dirty environments and poor sanitation and hygiene. Aim: The purpose of this study was to determine the contamination of Escherichia coli and Salmonella spp. and antibiotic resistance in chicken meat from traditional markets in the Gresik District. Methods: The samples were collected by random sampling following the general procedures of the FDA guidelines for meat sample handling. The samples were then transported in a cold box containing ice packs at approximately 4°C. Laboratory testing was conducted at the Veterinary Public Health Laboratory, Faculty of Veterinary Medicine, Wijaya Kusuma University, Surabaya. Samples were cultured on selective MacConkey Agar and Salmonella Shigella Agar, followed by Gram staining, biochemical tests, and antibiotic susceptibility testing on Mueller Hinton Agar using the Clinical and Laboratory Standards Institute (CLSI, 2022) guidelines. Results: The results of antibiotic resistance to E. coli showed resistance to amoxicillin 75% (47/61), ampicillin 75% (47/61), oxytetracycline 59% (36/61), streptomycin 49% (30/61), sulfonamide trimethoprim 44% (27 /61), ciprofloxacin 29% (18/61), gentamicin 27% (17/61), chloramphenicol 13% (8/61), and azithromycin 3% (2/61), while Salmonella spp. showed antibiotic resistance oxytetracycline 84% (27/32), azithromycin 65% (21/32), sulfonamide trimethoprim 53% (17/32), ampicillin 43% (14/32), streptomycin 34% (11/32), amoxicillin 31% (10/32), ciprofloxacin 15% (5/32), gentamicin 12% (4/32), and chloramphenicol 9% (3/32). Antibiotics that have experienced multidrug resistance (MDR) against E. coli bacteria by 42% (26/61) and Salmonella spp. by 43% (14/32). Conclusion: This study found high levels of antibiotic resistance in E. coli and Salmonella spp. isolated from chicken meat sold in traditional markets in Gresik District, with the highest resistance observed against amoxicillin, ampicillin, and oxytetracycline. MDR was detected in 42% of E. coli and 43% of Salmonella spp. isolates. These findings suggest the potential misuse of antibiotics in poultry production and underscore the need for better surveillance, hygiene control in markets, and responsible antibiotic use to prevent the transmission of resistant bacteria to humans. Keywords: Antibiotic resistance, Chicken meat, E. coli, Human health, Salmonella spp. IntroductionA good source of animal protein can come from chicken meat, because it has complete and easy to obtain essential amino acids (Yanestria et al., 2024), as well as simple processed chicken meat, relatively large stock on the market, and affordable prices, which make it liked by the people of Indonesia (Wibisono et al., 2023). Another reason is that chicken meat contains all of the required amino acids, vitamins, and minerals, making it a healthy source of animal protein for general consumption. Because of its high nutritional value, chicken meat is prone to bacterial development (Wardhana et al., 2021). Salmonella spp., Klebsiella spp., Citrobacter spp., and Escherichia coli are among the bacteria that can cause foodborne illness when chicken meat is exposed to an unsanitary environment (Permatasari et al., 2020; Effendi et al., 2021). Chicken meat is very easily contaminated by microbes because it has a high water content of 68.75%, pH, and nitrogen needed for decomposing microorganisms for growth (Januari et al., 2019). Many zoonotic diseases that can be transmitted through animal-based food products are caused by microorganisms and are therefore known as foodborne diseases (Khairullah et al., 2019; Ramandinianto et al., 2020a). Foodborne disease is a global problem that has an impact on food security and public health (Widodo et al., 2023). Pathogenic microorganisms that can cause foodborne disease include Staphylococcus aureus, Giardia sp., Vibrio cholerae, Cryptosporidium spp., Cronobacter sakazakii, Shigella spp., Campylobacter spp., Clostridium perfringens, Listeria monocytogenes, Bacillus cereus, E. coli, Clostridium botulinum, Salmonella spp., and Yersinia enterocolitica (Abebe et al., 2020). Escherichia coli is a bacterium in the digestive tract of animals and humans as normal flora, but some strains can be pathogenic (Prayudi et al., 2023), while Salmonella spp. can cause salmonellosis as the main foodborne disease, with 93 million cases of infection and 155,000–230,000 deaths worldwide each year in humans (Lamichhane et al., 2024). Foodborne pathogenic bacteria, such as E. coli, Salmonella, Streptococcus, Staphylococcus, and Campylobacter, have developed resistance to various antibiotics identified from livestock and food products of animal origin, such as chicken meat (Effendi et al., 2018a; Wibisono et al., 2020; Rafiq et al., 2022). Escherichia coli and Salmonella spp. bacteria are reported to be increasingly resistant to several antibiotics from year to year. Antimicrobial resistance is an important problem that often occurs because it can increase infection transmission, reduce the effectiveness of treatment, and increase health costs (Ramandinianto et al., 2020b; Khairullah et al., 2023). Antibiotic resistance in chicken meat contaminated with E. coli and Salmonella spp. has been widely reported. Escherichia coli bacteria are resistant to the antibiotics ampicillin, ciprofloxacin, streptomycin, cefepime, ceftriaxone, chloramphenicol, enrofloxacin, cifixime, erythromycin, tetracycline, tetracycline, ceftazidime, quinolone trimethoprim-sulfamethoxazole, chloramphenicol, oxytetracycline, ciprofloxacin, and gentamicin in chicken meat in Bangladesh, Indonesia, Malaysia, and Singapore (Akter et al., 2017; Hardiati et al., 2021; Ibrahim et al., 2021; Songsri et al., 2022; Lemlem et al., 2023). Escherichia coli and Salmonella spp. becomes important because it is associated with multidrug resistance (MDR) events (Brown et al., 2017; Wibisono et al., 2021; Widodo et al., 2022). Recent advances in nanotechnology have introduced nanoparticles as promising alternatives to conventional antibiotics due to their unique antimicrobial properties. Several studies have demonstrated that nanoparticles, such as silver, zinc oxide, and chitosan-based nanomaterials, exhibit broad-spectrum antibacterial activity, including against MDR pathogens like E. coli and Salmonella spp. These nanoparticles can disrupt bacterial membranes, generate reactive oxygen species, and interfere with cellular metabolism, making them effective even against bacteria with established resistance mechanisms. Their application in food preservation and surface sanitation could potentially reduce microbial contamination in the food supply chain, especially in traditional market environments where hygiene is often suboptimal (Adame et al., 2024; Cui et al., 2024; Shi et al., 2024; Lin et al., 2025 Shi et al., 2025). Traditional markets are places with high potential for contamination and microbial growth (Lyhs et al., 2012; Darmawan et al., 2020). Traders’ lack of awareness regarding the cleanliness and health of chicken meat sold in traditional markets can cause the meat to be contaminated with pathogenic microorganisms, and if it is not handled properly, it will have an adverse impact on health (Karanth et al., 2023). The purpose of this study was to determine E. coli and Salmonella spp. contamination and antibiotic resistance in chicken meat from traditional markets in the Gresik District. This research is an early warning effort against antibiotic resistance of several classes that are often used in the poultry industry, such as beta-lactams (amoxicillin and ampicillin), tetracyclines (oxytetracycline), macrolides (azithromycin), fluoroquinolones (ciprofloxacin), aminoglycosides (streptomycin and gentamicin), sulfonamide (trimethoprim sulfonamide), and chloramphenicol against contamination by E. coli and Salmonella spp. on chicken meat sold in traditional markets. To the best of our knowledge, this is the first report describing antibiotic resistance patterns in chicken meat from traditional markets in Gresik District. The novelty of this study lies in the observed resistance trends across multiple antibiotic classes that are commonly used in both poultry and human health, offering a broader public health perspective. Materials and MethodsSample collectionThis research was conducted from August to October 2022 at the Veterinary Public Health Laboratory, Faculty of Veterinary Medicine, Wijaya Kusuma University, Surabaya. Chicken meat samples were taken from 10 traditional markets in Gresik District, with a total sample of 71. The sampling technique was performed using random sampling, and the number of samples taken from each market was adjusted based on the number of chicken meat vendors present at each traditional market. Sampling was conducted once for each market and on the same day and time frame across all markets to minimize temporal bias. Samples were sent to the laboratory at a consistent temperature of aapproximately4°C after being placed in a cold box containing ice packs. The samples were processed by the Department of Veterinary Public Health Laboratory at the Faculty of Veterinary Medicine, Universitas Wijaya Kusuma Surabaya. Isolation and identification of E. coliThe isolated E. coli was first enriched in Brilliant Green Lactose Broth media (Merck, 105454) and incubated at 37°C for 18–24 hours. Following enrichment, the samples were streaked onto MacConkey Agar (MCA) as a selective medium and incubated at 35°C–37°C for 20–24 hours for bacterial isolation. Following the identification of E. coli colonies on MCA, pink rod-shaped Gram-negative bacteria were observed using a Gram staining kit (HiMedia, K001-1KT). Biochemical characterization using triple sugar iron agar (TSIA) (Merck,$ 103915) and IMViC tests—sulfide indole motility (SIM) (Merck,$ 105470), methyl red-Voges Proskauer (Merck,$ 105712), and Simmons citrate agar (Oxoid, CM155)—was performed for the identification and confirmation of pure colonies of E. coli based on the criteria outlined in Bergey’s Manual of Determinative Bacteriology (Tyasningsih et al., 2022). Presumptive E. coli colonies appeared pink to dark pink (lactose-fermenting) colonies on MCA. Colonies were further confirmed by Gram staining (Gram-negative rods) and a series of biochemical tests. The biochemical results showed urease (negative), SIM (motile, indole positive, H2S negative), TSIA (acid slant/acid butt without H2S), SCA (positive), MR (positive), and VP (negative), which are consistent with the typical biochemical profile of Escherichia coli. Isolation and identification of Salmonella spp.In order to accomplish pre-enrichment, chicken meat swabs were inoculated into 5 ml of buffered peptone water (BPW; Oxoid, Basingstoke, UK) and incubated for 24 hours at 37°C (Tarabees et al., 2017; Sharma et al., 2019). For selective enrichment, 1 ml of buffer peptone water was added to 10 ml of Tetrathionate Broth (TTB, Merck, Germany) for each culture, and the mixture was then incubated for 24 hours at 37°C. Salmonella-Shigella Agar (Sigma Aldrich, Germany) was streaked with one loopful of the culture in duplicate, and incubated for 24 hours at 37°C. After 24 hours, the plates were tested for the presence of probable Salmonella spp. Putative positive samples produced colorless colonies with black cores on the SSA plates. Additional Gram staining and biochemical analyses were performed based on the criteria outlined in Bergey’s Manual of Determinative Bacteriology (Wibisono et al., 2023). Characteristics of Salmonella spp. due to hydrogen sulfide (H2S) production. These colonies were considered presumptive Salmonella and were further subjected to Gram staining (Gram-negative rods) and a series of biochemical tests for confirmation. The biochemical tests included urease (negative), SIM (motile, H2S positive, indole negative), TSIA (alkaline slant/acid butt with H2S and gas production), SCA (positive), MR (positive), and VP (negative), which align with the typical biochemical characteristics of Salmonella spp. Antimicrobial susceptibility testThe antibiotic susceptibility of Salmonella spp. and E. coli isolates was assessed using the Kirby–Bauer disk diffusion technique, as recommended by the Clinical and Laboratory Standards Institute (CLSI, 2022). Following the manufacturer’s instructions, Mueller Hinton Agar (MHA) (Merck, 105437) was prepared, cooled to 45°C–50°C, and then placed into plates. After solidification of the agar, the plates were allowed to dry. The bacterial isolation broth culture that was grown for 18–24 hours was standardized by diluting it to McFarland’s standard. To remove excess inoculum load, the culture was drained after the bacterial isolates were first added to a standardized inoculum. The surfaces of the prepared MHA plates were then inoculated using a sterile swab stick. The MHA plate containing the inoculation was then covered and left to dry for a short while at room temperature (29°C). Once the agar surface had dried for a few minutes, the antibiotic-impregnated discs were carefully inserted using sterile forceps on the inoculated MHA plates. Data analysis was carried out in a qualitative descriptive manner by presenting the results of isolation and identification of resistance to penicillin (amoxicillin and ampicillin), tetracycline (oxytetracyclineco), macrolides (azithromycin), fluoroquinolones (ciprofloxacin), aminoglycosides (streptomycin and gentamicin), sulfonamide (sulfonamide trimethoprim), and chloramphenicol against E. coli and Salmonella spp. on chicken meat from traditional markets in Gresik district. MHA plates were incubated at 37°C for 18–24 hours, and a ruler was used to measure the widths of the inhibitory zones that developed on the plates to the closest millimeter. The CLSI was used to note and analyze the results (CLSI, 2022). The sensitivity of Salmonella spp. and E. coli bacteria to more than three kinds of antibiotics is known as multidrug resistance, and it is a consequence of resistance (Ansharieta et al., 2021a). The results were analyzed descriptively using Microsoft Excel to calculate the frequencies and percentages of bacterial contamination and antibiotic resistance patterns. No inferential statistical tests were applied because the study aimed to provide an early descriptive overview.
Fig. 1. Escherichia coli colonies on MCA selective media (A) and Salmonella spp. on SSA selective media (B). ResultBased on the results of this study, a total of 71 chicken meat samples were collected from 10 traditional markets in Gresik District. Of these, 61 samples (86%) were contaminated with E. coli, and 32 samples (45%) were contaminated with Salmonella spp. The results of isolation of E. coli bacteria on MCA media showed colonies with small, round shapes, dry, irregular, and pink color, whereas Salmonella spp. used TB media to increase the number of colonies. Then isolated using (SSA) media with a transparent shape and small black spots. The colonies of E. coli and Salmonella spp. are shown in Figure 1. Based on the results of this study, 86% (61/71) of the samples gave positive results due to contamination by E. coli bacteria. Chicken meat from the Menganti traditional market showed positive results for E. coli bacteria at 100% (11/11), Balong Panggang (9/9), Manyar (9/9), Gresik Kota, (7/7), and Duduk Sampeyan (3/3). Samples of chicken meat from the Wedoro Anom traditional market show 80% (4/5). Chicken meat from the Driyorejo and Kebomas traditional markets yielded a positive result of 71% (5/7). Chicken meat from the Benjeng traditional market was 67% (4/6). Chicken meat from the Cerme traditional market is 57% (4/7). Out of 71 meat samples, 32 (45%) were contaminated with Salmonella spp. The highest prevalence was observed in samples from Duduk Sampeyan Market (100%, 3/3), followed by Wedoro Anom Market (80%, 4/5), Driyorejo and Gresik Kota Markets (57%, 4/7 each), and Benjeng Market (50%, 3/6). Samples from the Menganti Market showed a prevalence of 45% (5/11), whereas those from the Balong Market showed a prevalence of 44% (4/9). Cerme and Kebomas Markets each showed a prevalence of 28% (2/7), and the lowest prevalence was found in Manyar Market (11%, 1/9). The results of E. coli and Salmonella spp. contamination in chickens are presented in Table 1. Antibiotic sensitivity test against E. coli and Salmonella spp. tested on MHA media. Sensitivity results showed a clear inhibition zone around the antibiotic disc. The results of the sensitivity test were compared with those of the Enterobacteriaceae group adapted according to the Clinical and Laboratory Standards Institute (CLSI, 2022). If there are more than or equal to three types of antibiotics from different groups showing resistance, then the antibiotics are categorized as MDR. The results of the sensitivity test are presented in Table 2. The antibiotic resistance profile of E. coli isolates from chicken meat collected in 10 traditional markets in Gresik District showed high levels of resistance to amoxicillin and ampicillin, each at 75% (47/61). Resistance to oxytetracycline was observed in 59% (36/61) of the isolates, followed by streptomycin 49% (30/61), sulfonamide trimethoprim 44% (27/61), ciprofloxacin 29% (18/61), gentamicin 27% (17/61), chloramphenicol 13% (8/61), and azithromycin 3% (2/61). In Salmonella spp. isolates, the highest resistance was observed against oxytetracycline (84% (27/32), followed by azithromycin 65% (21/32), sulfonamide trimethoprim 53% (17/32), ampicillin 43% (14/32), streptomycin 34% (11/32), amoxicillin 31% (10/32), ciprofloxacin 15% (5/32), gentamicin 12% (4/32), and chloramphenicol 9% (3/32). MDR, defined as resistance to three or more antibiotic classes, was identified in 42% (26/61) of E. coli isolates and 43% (14/32) of Salmonella spp. isolates (Table 3). Table 1. Contamination results of E. coli and Salmonella spp. in chicken.
DiscussionEscherichia coli and Salmonella spp. are Gram-negative bacteria that can contaminate foodstuffs originating from animal products such as chicken meat (Obe et al., 2020; Putri et al., 2023). Based on the results of this study, the prevalence of E. coli originating from chicken meat in traditional markets in the Gresik District was 86% (61/71). This result is much higher than Sri Lanka 66.8% (167/250) (Ranasinghe et al., 2022), 50% (6/12) in Denpasar (Pratiwi et al., 2022), Lamongan district 11% (3/26) (Kartikasari et al., 2019), but lower than that of Pakistan (95.6%) of frozen chicken carcasses (Eltai et al., 2020). This is because E. coli can contaminate food when slaughtering animals, unhygienic handling, and unclean market environmental conditions for food storage and processing (Effendi et al., 2018b; Kendek et al., 2024). The results showed that chicken meat from 10 traditional markets in the Gresik district was contaminated with Salmonella spp. by 45% (32/71). This result is much higher than that of Salmonella in Nigeria, 32.1% (17/53) (Adeyanju and Ishola, 2014), Makassar, 12.5% (3/24), but lower than Malaysia, 84.4% (Shafini et al., 2017). This is influenced by poor sanitation, personal hygiene, open sales areas, meat that is stacked with other meat, and a dirty environment (Saravanan et al., 2015; Ansharieta et al., 2021b). Escherichia coli and Salmonella spp. can cause diseases of the urinary tract, diarrhea, septicemia, and meningitis (Bhattarai et al., 2023; Pokharel et al., 2023). Prevention of contamination by E. coli and Salmonella spp. bacteria can be done by sanitizing cages, clean environment, and cross-contamination, as in traditional markets synonymous with unsterile slaughter, disorderly environment, dirty, less clean water, and meat that is sold just placed without using clean mats (Pradika et al., 2019; Widodo et al., 2023). Chicken meat contaminated with E. coli and Salmonella spp. can be consumed if handled properly, such as meat cooked at a high temperature of at least 70°C (Afshari et al., 2018). Water quality as a cause of contamination of E. coli and Salmonella spp. with the characteristic quality of water that is cloudy and smells of ammonia. This is in accordance with Dameanti et al. (2023), who reported that the presence of E. coli in water indicates that water can be contaminated with animal waste. Contaminated water contains E. coli, Salmonella spp., and S. aureus, which can contaminate chicken meat (Shafini et al., 2017; Ranasinghe et al., 2022). The observed increase in antibiotic resistance in chicken meat contaminated with E. coli and Salmonella spp. is likely attributable to cross-contamination during handling and processing at traditional markets. Such cross-contamination between meat products and market workers may facilitate the horizontal transmission of resistant bacteria, thereby contributing to the emergence and spread of multidrug-resistant strains (Fanissa et al., 2022). Based on the results of this study, a high incidence of resistance was observed in meat contaminated with E. coli bacteria, namely amoxicillin 75% (47/61), ampicillin 75% (47/61) and oxytetracycline 59% (36/61), streptomycin 49% (30/61), trimethoprim sulfonamide 44% (27/61). The results of the study of Salmonella spp. showed high resistance to oxytetracycline 84% (27/32), azithromycin 65% (21/32), sulfonamide trimethoprim 53% (17/32), ampicillin 43% (14/32), streptomycin 34% (11/32), and amoxicillin 31% (10/32). The results of previous studies showing resistance to ampicillin in chicken meat showed resistance at a percentage of 90% (Rahmaniar et al., 2021). The use of antibiotics that are often used, namely ampicillin, amoxicillin, and oxytetracycline, is very susceptible to resistance because these antibiotics are easy to reach and relatively cheap (Manyi-Loh et al., 2018). Table 2. Antibiotic resistance test results against E. coli and Salmonella spp.
Table 3. Antimicrobial resistance pattern of multidrug resistance E. coli and Salmonella spp.
Increased mortality and morbidity, resulting in increased infections, are mediated by antibiotic resistance to pathogens (Singh et al., 2018). The mechanism of penicillin antibiotics, consisting of ampicillin and amoxicillin, works by inhibiting the synthesis and cutting of the beta-lactamase ring (Bush and Bradford, 2016). The tetracycline class of antibiotics (oxytetracycline) has a broad spectrum that functions as a bacteriostatic agent and can prevent diseases caused by both Gram-positive and negative bacteria. Macrolide class antibiotics (azithromycin) work by inhibiting the 50S ribosomal subunit, which is bacteriostatic and bactericidal (Zieliński et al., 2021), and aminoglycosides (streptomycin and gentamicin) are bactericidal, which work by inhibiting bacterial protein synthesis in the 30S subunit and are broad-spectrum (Krause et al. 2016). Multidrug resistance refers to resistance to three or more different antibiotic classes (Khairullah et al., 2022). The incidence of multidrug resistance, especially in Enterobacteriaceae bacteria, has increased every year, with a percentage of 52.5% (Bushen et al., 2021). Based on the results of this study, chicken meat contaminated with E. coli bacteria was found to have an MDR of 42% (26/61) and Salmonella spp. of 43% (14/32) confirmed multidrug resistance. The highest number of MDR cases has also been reported in Bangladesh and Vietnam (Nahar et al., 2014; Vounba et al., 2019). This is due to the use of inappropriate antibiotics, inappropriate time of use, and inappropriate route of administration (Harris et al., 2015). Control measures must be active to prevent the emergence and spread of multidrug resistance Salmonella spp. Education is important for limiting inappropriate antibiotic use and evaluating antibiotic use programs in the livestock industry (Manyi-Loh et al., 2018). The incidence of E. coli and Salmonella spp. bacterial contamination on chicken meat from the Gresik District Traditional Market showed a positive result of 100%, whereas the level of resistance to the antibiotics penicillin, macrolide, fluoroquinolone, chloramphenicol, and tetracycline classes showed different results. The highest level of antibiotic resistance to E. coli was observed in the penicillin class of antibiotics, followed by tetracycline, macrolides, fluoroquinolones, and chloramphenicol. In Salmonella spp. bacteria, the highest antibiotic resistance was observed in the tetracycline, macrolide, penicillin, fluoroquinolone, and chloramphenicol groups. The incidence of multidrug resistance in E. coli was 42% (26/61), and that in Salmonella spp. showed multidrug resistance results with a percentage of 43% (14/32). ConclusionThis study found a high prevalence of E. coli (86%) and Salmonella spp. (45%) in chicken meat sold at traditional markets in the Gresik District. The incidence of MDR was observed in 42% and 43% of E. coli and Salmonella spp. isolates, respectively. These findings raise public health concerns because the consumption of contaminated chicken meat may contribute to the spread of antibiotic-resistant bacteria in humans. Therefore, routine monitoring of chicken meat sold in traditional markets and stricter regulation of antimicrobial usage in poultry farming are essential. Governments must implement continuous and proper surveillance of antimicrobial use to minimize the risk of resistance development and protect public health. AcknowledgmentsThe authors would like to thank the Universitas Airlangga. Conflict of interestThe authors declare no conflict of interest. FundingThe authors would like to acknowledge Ebonyi State University, Abakaliki, Nigeria, and Lembaga Penelitian dan Pengabdian Masyarakat Universitas Airlangga, Indonesia, for their support. This study was partly supported by the International Research Consortium, Lembaga Penelitian dan Pengabdian Masyarakat, Universitas Airlangga, Surabaya, Indonesia, Year 2024, with grant number: 171/UN3.LPPM/PT.01.03/2024. Author’s contributionsFJW, WT, and MHE: Conceived, designed, and coordinated the study. SS, DPD, and IAK: Designed data collection tools, supervised the field sample and data collection, and laboratory work as well as data entry. RPR, ARK, and BB: Validation, supervision, and formal analysis. DCN and VR: Contributed reagents, materials, and analysis tools. DAAK, RZA, and IBM: Statistical analysis and interpretation, and preparation of the manuscript. All authors have read, reviewed, and approved the final manuscript. Data availabilityAll data are available in the manuscript. ReferencesAbebe, E. Gugsa, G. and Ahmed, M. 2020. Review of major food-borne zoonotic bacterial pathogens. J. Trop. Med. 2020(1), 4674235. Adame, M.Y., Shi, C., Li, C., Aziz, T., Alharbi, M., Cui, H. and Lin, L. 2024. Fabrication and characterization of pullulan/tapioca starch-based antibacterial films incorporated with Litsea cubeba essential oil for meat preservation. Int. J. Biol. Macromol. 268(Pt 1), 139799. Adeyanju, G.T. and Ishola, O. 2014. Salmonella and Escherichia coli contamination of poultry meat from a processing plant and retail market in Ibadan, Oyo State, Nigeria. Springerplus 3(1), 139. Afshari, A., Baratpour, A., Khanzade, S. and Jamshidi, A. 2018. Salmonella Enteritidis and Salmonella Typhimorium identification in poultry carcasses. Iran J. Microbiol. 10(1), 45–50. Akter, S., Ferdousi, R.S. and Siddiqua, M. 2017. Bacterial isolates and antimicrobial susceptibility of children with acute diarrhea at Ibn Sina Medical College, Bangladesh. Indones. J. Med. Health 8(2), 80–86. Ansharieta, R., Effendi, M.H. and Plumeriastuti, H. 2021b. Genetic identification of Shiga toxin encoding gene from cases of multidrug resistance (MDR) Escherichia coli isolated from raw milk. Trop. Anim. Sci. J. 44(1), 10–15. Ansharieta, R., Ramandinianto, S.C., Effendi, M.H. and Plumeriastuti, H. 2021a. Molecular identification of the blaCTX-M and blaTEM genes encoding extended-spectrum ß-lactamase (ESBL) producing Escherichia coli isolated from raw cow’s milk in East Java, Indonesia. Biodiversitas 22(4), 1600–1605. Bhattarai, H.B., Rayamajhi, S., Bhattarai, M., Bhandari, S., Acharya, S., Uprety, M., Yonghang, S., Kadel, G., Bhusal, S. and Joshi, S. 2023. Salmonella meningitis, an unusual complication of Salmonella species: a case report from Nepal. Ann. Med. Surg. (Lond). 85(5), 2145–2147. Brown, A.C., Grass, J.E., Richardson, L.C., Nisler, A.L., Bicknese, A.S. and Gould, L.H. 2017. Antimicrobial resistance in Salmonella that caused foodborne disease outbreaks: United States, 2003-2012. Epidemiol. Infect. 145(4), 766–774. Bush, K. and Bradford, PA 2016. β-Lactams and β-Lactamase Inhibitors: an overview. Cold spring Harb. Perspect. Med. 6(8), a025247. Bushen, A., Tekalign, E. and Abayneh, M. 2021. Drug- and multidrug-resistance patterns of Enterobacteriaceae isolated from droppings of healthy chickens on a poultry farm in Southwest Ethiopia. Infect. Drug Resist. 14(1), 2051–2058. CLSI. 2022. M100 Performance Standards for Antimicrobial. 32th ed. Wayne City, Pennsylvania: Clinical and Laboratory Standards Institute. Cui, H., Gao, J., Khin, M., Aziz, T., Al-Asmari, F., Alamri, A., Alhomrani, M. and Lin, L 2024. Preparation and application of a pH-sensitive protein nanofibre membrane loaded with alizarin and curcumin for meat preservation. Packag. Technol. Sci. 37(8), 793–807. Darmawan, A., Muslimin, L., Arifah, S. and Mahatmi, H. 2020. Salmonella Spp. contamination of broiler chicken meat werw at several traditional market in Makassar. Indones. Med. Vet. 9(2), 168–176. Dameanti, F.N.A.P., Yanestria, S.M., Widodo, A., Effendi, M.H., Plumeriastuti, H., Tyasningsih, W., Sutrisno, R. and Akramsyah, M.A. 2023. Incidence of Escherichia coli producing extended-spectrum beta-lactamase (ESBL) in the wastewater of dairy farms in East Java, Indonesia. Biodiversitas 24(2), 1143–1150. Effendi, M.H., Oktavianto, A. and Hastutiek, P. 2018a. Tetracycline resistance gene in Streptococcus agalactiae isolated from bovine subclinical mastitis in Surabaya, Indonesia. Philip. J. Vet. Med. 55(Special Issue), 115–120. Effendi, M.H., Harijani, N., Yanestria, S.M. and Hastutiek, P. 2018b. Identification of Shiga toxin-producing Escherichia coli in raw milk samples from dairy cows in Surabaya, Indonesia. Philipp. J. Vet. Med. 55(SI), 109–114. Effendi, M.H., Tyasningsih, W., Yurianti, Y.A., Rahmahani, J., Harijani, N. and Plumeriastuti, H. 2021. Presence of multidrug resistance (MDR) and extended-spectrum beta-lactamase (ESBL) in Escherichia coli isolated from cloacal swabs of broilers in several wet markets in Surabaya, Indonesia. Biodiversitas 22(1), 304–310. Eltai, N.O., Yassine, H.M., El-Obeid, T., Al-Hadidi, S.H., Al Thani, A.A. and Alali, W.Q. 2020. Prevalence of antibiotic-resistant Escherichia coli isolates from local and imported retail chicken carcasses. J. Food Prot. 83(12), 2200–2208. Fanissa, F., Effendi, M.H., Tyasningsih, W. and Ugbo, E.N. 2022. Multidrug-resistant Salmonella species in chicken meat sold at Surabaya Traditional Markets, Indonesia. Biodiversitas 23(6), 2823–2829. Hardiati, A., Safika, S., Wibawan, I.W.T., Indrawati, A. and Pasaribu, F.H. 2021. Isolation and detection of antibiotic resistance genes of Escherichia coli from broiler farms in Sukabumi, Indonesia. J. Adv. Vet. Anim. Res. 8(1), 84–90. Harris, P., Paterson, D. and Rogers, B. 2015. Facing the challenge of multidrug-resistant Gram-negative bacilli in Australia. Med. J. Aust. 202(5), 243–246. Ibrahim, S., Hoong, L.W., Siong, Y.L., Mustapha, Z., Zalati, C.W.S.C.W., Aklilu, E., Mohamad, M. and Kamaruzzaman, N.F. 2021. Prevalence of antimicrobial resistance (AMR) Salmonella spp. and Escherichia coli isolated from broilers in the East Coast of Peninsular Malaysia. Antibiotics (Basel) 10(5), 579. Januari, C., Sudarwanto, M.B. and Purnawarman, T. 2019. Antibiotic resistance in Escherichia coli isolated from chicken meat of traditional markets in the city of Bogor. J. Vet. 20(1), 125–131. Karanth, S., Feng, S., Patra, D. and Pradhan, A.K., 2023. Linking microbial contamination to food spoilage and food waste: the role of smart packaging, spoilage risk assessments, and date labeling. Front. Microbiol. 14(1), 1198124. Kartikasari, AM, Hamid, I.S., Purnama, M.T.E., Damayanti, R., Fikri, F. and Praja, R.N., 2019. Isolation and identification of Escherichia coli as bacterial contamination in broiler chicken meat in poultry Slaughterhouse Lamongan District. J. Med. Vet. 2(1), 66–71. Kendek, I.A., Putri, M.F.R., Wibisono, F.J., Effendi, M.H., Tyasningsih, W., Ugbo, E.N. and Agumah, NB 2024. Molecular detection of hlyF gene on multidrug resistance of avian pathogenic Escherichia coli isolated from ducks on wet markets in Surabaya, Indonesia. Biodiversitas 25(3), 1246–1252. Khairullah, A.R., Kurniawan, S.C., Effendi, M.H., Sudjarwo, S.A., Ramandinianto, S.C., Widodo, A., Riwu, K.H.P., Silaen, O.S.M. and Rehman, S. 2023. A review of new livestock-associated methicillin-resistant Staphylococcus aureus from pig farms. Vet. World 16(1), 46–58. Khairullah, A.R., Raharjo, D., Rahmahani, J., Suwarno, Tyasningsih, W. and Harijani, N. 2019. Antibiotics resistant at Staphylococcus aureus and Streptococcus sp. isolated from bovine mastitis in Karangploso, East Java, Indonesia. Indian J. Forensic Med. Toxicol. 13(4), 439–444. Khairullah, A.R., Sudjarwo, S.A., Effendi, M.H., Ramandininto, S.C., Gelolodo, M.A., Widodo, A., Riwu, K.H.P., Kurniawati, D.A. and Rehman, S. 2022. Profile of multidrug resistance and methicillin-resistant Staphylococcus aureus (MRSA) on dairy cows and risk factors from farmer. Biodiversitas 23(6), 2853–2858. Krause, K.M., Serio, A.W., Kane, T.R. and Connolly, L.E. 2016. Aminoglycosides: an overview. Cold spring Harb. Perspect. Med. 6(6), a027029. Lamichhane, B., Mawad, A.M.M., Saleh, M., Kelley, W.G., Harrington, P.J. 2nd, Lovestad, C.W., Amezcua, J., Sarhan, M.M., El Zowalaty, M.E., Ramadan, H., Morgan, M. and Helmy, Y.A. 2024. Salmonellosis: an overview of epidemiology, pathogenesis, and innovative approaches to mitigate the antimicrobial-resistant infections. Antibiotics (Basel) 13(1), 76. Lemlem, M., Aklilu, E., Mohammed, M., Kamaruzzaman, F., Zakaria, Z., Harun, A. and Devan, S.S. 2023. Molecular detection and antimicrobial resistance profiles of extended-spectrum beta-lactamase (ESBL) producing Escherichia coli in broiler chicken farms in Malaysia. PLoS One 18(5), e0285743. Lyhs, U., Ikonen, I., Pohjanvirta, T., Raninen, K., Perko-Mäkelä, P. and Pelkonen, S. 2012. Extraintestinal pathogenic Escherichia coli in poultry meat products on the Finnish retail market. Acta Vet. Scand. 54(1), 64. Lin, L., Liu, X., Shi, C., Chen, X., Aziz, T., Al-Asmari, F., Mohamed, A. and Cui, H. 2025. Preparation and characterization of chitosan-Tremella fuciformis polysaccharide edible films for meat preservation. Packag. Technol. Sci. 38(3), 211–226. Manyi-Loh, C., Mamphweli, S., Meyer, E. and Okoh, A. 2018. Antibiotic use in agriculture and its consequential resistance in environmental sources: potential public health implications. Molecules 23(4), 795. Nahar, A., Siddiquee, M., Nahar, S., Anwar, K.S., Ali, S.I. and Islam, S. 2014. Multidrug resistant-proteus mirabilis isolated from chicken droppings in commercial poultry farms: biosecurity concern and emerging public health threat in Bangladesh. J. Biosafety Health Educ. 2(2), 120. Obe, T., Nannapaneni, R., Schilling, W., Zhang, L, McDaniel, C. and Kiess, A. 2020. Prevalence of Salmonella enterica on poultry processing equipment after completion of sanitization procedures. Poult. Sci. 99(9), 4539–4548. Permatasari, D.A., Witaningrum, AM, Wibisono, F.J. and Effendi, M.H. 2020. Detection and prevalence of multidrug-resistant Klebsiella pneumoniae strains isolated from poultry farms in Blitar, Indonesia. Biodiversitas 21(10), 4642–4647. Pokharel, P., Dhakal, S. and Dozois, C.M. 2023. Diversity of Escherichia coli pathotypes and vaccination strategies against this versatile bacterial pathogen. Microorganisms 11(2), 344. Pradika, A.Y., Chusniati, S., Purnama, M.T.E., Effendi, M.H., Yudhana, A. and Wibawati, P.A. 2019. Total Test of Escherichia coli on fresh cow milk at dairy farmer cooperative (KPSP) Karyo Ngremboko Purwoharjo Banyuwangi. J. Med. Vet. 2(1), 1–6. Pratiwi, P.I.A., Ratih, G.A.M. and Sudarmanto, I.G. 2022. Identification of Escherichia coli contamination and contaminant factors in chicken meat in the ketapian market, East Denpasar. J. Keshan. Lingkung. 12(1), 45–53. Prayudi, S.K.A., Effendi, M.H., Lukiswanto, B.S., Az Zahra, R.L., Benjamin, M.I., Kurniawan, S.C., Khairullah, A.R., Silaen, O.S.M., Lisnanti, E.F., Baihaqi, Z.A., Widodo, A. and Riwu, K.H.P. 2023. Detection of genes on Escherichia coli producing extended spectrum β-lactamase isolated from the small intestine of ducks in traditional markets Surabaya City, Indonesia. J. Adv. Vet. Res. 13(8), 1600–1608. Putri, M.F.R., Kendek, I.A., Wibisono, F.J., Effendi, M.H., Rahardjo, D., Tyasningsih, W. and Ugbo, E.N. 2023. Molecular detection of iron gene on multidrug resistant avian fecal Escherichia coli isolated from broiler on traditional markets in Surabaya, Indonesia. Biodiversitas 24(12), 6454–6460. Rafiq, K., Islam, M.R., Siddiky, N.A., Samad, M.A., Chowdhury, S., Hossain, K.M.M., Rume, F.I., Hossain, M.K., Mahbub-E-Elahi, A., Ali, M.Z., Rahman, M., Amin, M.R., Masuduzzaman, M., Ahmed, S., Rumi, N.A. and Hossain, M.T. 2022. Antimicrobial resistance profile of common foodborne pathogens recovered from livestock and poultry in Bangladesh. Antibiotics (Basel) 11(11), 1551. Rahmaniar, R.P., Widhowati, D. and Hidayah, N. 2021. Phenotypic antibiotic resistance and TetA gene detection in chicken liver samples at the Dukuh Kupang market, Surabaya. J. Trop. Anim. Vet. Sci. 11(3), 284–290. Ramandinianto, S.C., Khairullah, A.R., Effendi, M.H. and Hestiana, E.P. 2020b. Profile of multidrug resistance (MDR) and methicillin-resistant Staphylococcus aureus (MRSA) on dairy farms in East Java province, Indonesia. Indian J. Forensic Med. Toxicol. 14(4), 3439–3445. Ramandinianto, S.S.C., Khairullah, A.R., Effendi, M.H., Tyasningsih, W. and Rahmahani, J. 2020a. Detection of enterotoxin type B gene on methicillin resistant Staphylococcus aureus (MRSA) isolated from raw milk in East Java, Indonesia. Syst. Rev. Pharm. 11(7), 290–298. Ranasinghe, R.A.S.S., Satharasinghe, D.A., Anwarama, P.S., Parakatawella, P.M.S.D.K., Jayasooriya, L.J.P.A.P., Ranasinghe, R.M.S.B.K., Rajapakse, R.P.V.J., Huat, J.T.Y., Rukayadi, Y., Nakaguchi, Y., Nishibuchi, M., Radu, S. and Premarathne, J.M.K.J.K. 2022. Prevalence and antimicrobial resistance of Escherichia coli in chicken meat and edible poultry organs collected from retail shops and supermarkets of North Western Province in Sri Lanka. J. Food Qual. 2022(1), 8962698. Saravanan, S., Purushothaman, V., Ramasamy, T., Krishna, G., Sukumar, K., Srinivasan, P., Gowthaman, V., Balusamy, M., Atterbury, R. and Kuchipudi, S.V. 2015. Molecular epidemiology of nontyphoidal Salmonella in poultry and poultry products in India: implications for human health. Indian J. Microbiol. 55(3), 319–326. Shafini, A.B., Son, R., Mahyudin, N.A., Rukayadi, Y. and Zainazor, T.C.T. 2017. Prevalence of Salmonella spp. in chicken and beef from retail outlets in Malaysia. Int. Food Res. J. 24(1), 437–449. Sharma, P., Kumari, B., Dahiya, S., Kulsum, U., Kumar, S., Manral, N., Pandey, S., Kaur, P., Sood, S., Das, B.K. and Kapil, A. 2019. Azithromycin resistance mechanisms in typhoidal salmonellae in India: a 25 years analysis. Indian J. Med. Res. 149(3), 404–411. Shi, C., Jia, L., Tao, H., Hu, W., Li, C., Aziz, T., Al-Asmari, F., Sameeh, M.Y., Cui, H. and Lin, L. 2024. Fortification of cassava starch edible films with Litsea cubeba essential oil for chicken meat preservation. Int. J. Biol. Macromol. 276(Pt 2), 133920. Shi, C., Xu, R., Hu, W., Aziz, T., Alhomrani, M., Cui, H. and Lin L 2025. Fabrication of alginate dialdehyde-gelatin crosslinked hydrogels incorporated with cinnamaldehyde nanoparticles for meat preservation. Int. J. Biol. Macromol. 298(1), 140063. Singh, A.K., Das, S., Singh, S., Gajamer, V.R., Pradhan, N., Lepcha, Y.D. and Tiwari, H.K. 2018. Prevalence of antibiotic resistance in commensal Escherichia coli among children in rural hill communities of Northeast India. PLoS One 13(6), e0199179. Songsri, J., Mala, W., Wisessombat, S., Siritham, K., Cheha, S., Noisa, N., Wongtawan, T. and Klangbud, W.K. 2022. First isolation of verocytotoxin-producing Escherichia coli O157:H7 from sports animals in Southern Thailand. Vet. World 15(9), 2275–2284. Tarabees, R., Elsayed, M.S.A., Shawish, R., Basiouni, S. and Shehata, A.A. 2017. Isolation and characterization of Salmonella enteritidis and Salmonella typhimurium from chicken meat in Egypt. J. Infect. Dev. Ctries. 11(4), 314–319. Tyasningsih, W., Ramandinianto, S.C., Ansharieta, R., Witaningrum, A.M., Permatasari, D.A., Wardhana, D.K., Effendi, M.H. and Ugbo, E.N. 2022. Prevalence and antibiotic resistance of Staphylococcus aureus and Escherichia coli isolated from raw milk in East Java, Indonesia. Vet. World 15(8), 2021–2028. Vounba, P., Arsenault, J., Bada-Alambédji, R. and Fairbrother, J.M. 2019. Pathogenic potential and the role of clones and plasmids in beta-lactamase-producing E. coli from chicken feces in Vietnam. BMC Vet. Res. 15(1), 106. Wardhana, D.K., Haskito, A.E.P., Purnama, M.T.E., Safitri, D.A. and Annisa, S. 2021. Detection of microbial contamination in chicken meat from local markets in Surabaya, East Java, Indonesia. Vet. World 14(12), 3138–3143. Wibisono, F.J., Rahmaniar, R.P., Syaputra, D.E., Zuriya, Z., Aziz, K.M., Ikeng, L.D., Effendi, M.H. and Bernard, A.N. 2023. Risk factors for Nontyphoidal Salmonella contamination in chicken meat: a cross-sectional study on traditional markets in Surabaya. Adv. Life Sci. 10(2), 282–288. Wibisono, F.J., Sumiarto, B., Untari, T., Effendi, M.H., Permatasari, D.A. and Witaningrum, AM 2021. Molecular identification of the CTX gene of extended spectrum beta-lactamases (ESBL) producing Escherichia coli on layer chicken in Blitar, Indonesia. J. Anim. Plant Sci. 31(4), 6–9. Wibisono, F.M., Wibisono, F.J., Effendi, M.H., Plumeriastuti, H., Hidayatullah, A.R., Hartadi, E.B. and Sofiana, E.D. 2020. A review of salmonellosis on poultry farms: public health importance. Syst. Rev Pharm. 11(9), 481–486. Widodo, A., Lamid, M., Effendi, M.H., Khairullah, A.R., Riwu, K.H.P., Yustinasari, L.R., Kurniawan, S.C., Ansori, A.N.M., Silaen, O.S.M. and Dameanti, F.N.A.E.P. 2022. Antibiotic sensitivity profile of multidrug-resistant (MDR) Escherichia coli isolated from dairy cow milk in Probolinggo, Indonesia. Biodiversitas 23(10), 4971–4976. Widodo, A., Lamid, M., Effendi, M.H., Khailrullah, A.R., Kurniawan, S.C., Silaen, O.S.M., Riwu, K.H.P., Yustinasari, L.R., Afnani, D.A., Dameanti, F.N.A.E.P. and Ramandinianto, S.C. 2023. Antimicrobial resistance characteristics of multidrug resistance and extended-spectrum beta-lactamase producing Escherichia coli from several dairy farms in Probolinggo, Indonesia. Biodiversitas 24(1), 215–221. Yanestria, S.M., Effendi, M.H., Tyasningsih, W., Moses, I.B., Khairullah, A.R., Kurniawan, S.C., Dameanti, F.N.A.E.P., Ikaratri, R., Pratama, J.W.A., Sigit, M., Hasib, A. and Silaen, O.S.M. 2024. Antimicrobial resistance patterns and genes of Campylobacter jejuni isolated from chickens in Pasuruan, Indonesia. Open Vet. J. 14(3), 759–768. Zieliński, W., Korzeniewska, E., Harnisz, M., Drzymała, J., Felis, E. and Bajkacz, S. 2021. Wastewater treatment plants as a reservoir of integrase and antibiotic resistance genes: an epidemiological threat to workers and environment. Environ. Int. 156(1), 106641. | ||
| How to Cite this Article |
| Pubmed Style Wibisono FJ, Effendi MH, Tyasningsih W, Rahmaniar RP, Khairullah AR, Kendek IA, Budiastuti B, Rianto V, Nico DC, Kurniasih DAA, Salwa S, Diningrum DP, Moses IB, Ahmad RZ. Antibiotic resistance profiles of Escherichia coli and Salmonella spp. isolated from chicken meat sold in traditional markets in Gresik District, East Java, Indonesia. Open Vet. J.. 2025; 15(5): 2160-2170. doi:10.5455/OVJ.2025.v15.i5.34 Web Style Wibisono FJ, Effendi MH, Tyasningsih W, Rahmaniar RP, Khairullah AR, Kendek IA, Budiastuti B, Rianto V, Nico DC, Kurniasih DAA, Salwa S, Diningrum DP, Moses IB, Ahmad RZ. Antibiotic resistance profiles of Escherichia coli and Salmonella spp. isolated from chicken meat sold in traditional markets in Gresik District, East Java, Indonesia. https://www.openveterinaryjournal.com/?mno=242972 [Access: January 24, 2026]. doi:10.5455/OVJ.2025.v15.i5.34 AMA (American Medical Association) Style Wibisono FJ, Effendi MH, Tyasningsih W, Rahmaniar RP, Khairullah AR, Kendek IA, Budiastuti B, Rianto V, Nico DC, Kurniasih DAA, Salwa S, Diningrum DP, Moses IB, Ahmad RZ. Antibiotic resistance profiles of Escherichia coli and Salmonella spp. isolated from chicken meat sold in traditional markets in Gresik District, East Java, Indonesia. Open Vet. J.. 2025; 15(5): 2160-2170. doi:10.5455/OVJ.2025.v15.i5.34 Vancouver/ICMJE Style Wibisono FJ, Effendi MH, Tyasningsih W, Rahmaniar RP, Khairullah AR, Kendek IA, Budiastuti B, Rianto V, Nico DC, Kurniasih DAA, Salwa S, Diningrum DP, Moses IB, Ahmad RZ. Antibiotic resistance profiles of Escherichia coli and Salmonella spp. isolated from chicken meat sold in traditional markets in Gresik District, East Java, Indonesia. Open Vet. J.. (2025), [cited January 24, 2026]; 15(5): 2160-2170. doi:10.5455/OVJ.2025.v15.i5.34 Harvard Style Wibisono, F. J., Effendi, . M. H., Tyasningsih, . W., Rahmaniar, . R. P., Khairullah, . A. R., Kendek, . I. A., Budiastuti, . B., Rianto, . V., Nico, . D. C., Kurniasih, . D. A. A., Salwa, . S., Diningrum, . D. P., Moses, . I. B. & Ahmad, . R. Z. (2025) Antibiotic resistance profiles of Escherichia coli and Salmonella spp. isolated from chicken meat sold in traditional markets in Gresik District, East Java, Indonesia. Open Vet. J., 15 (5), 2160-2170. doi:10.5455/OVJ.2025.v15.i5.34 Turabian Style Wibisono, Freshinta Jellia, Mustofa Helmi Effendi, Wiwiek Tyasningsih, Reina Puspita Rahmaniar, Aswin Rafif Khairullah, Irfan Alias Kendek, Budiastuti Budiastuti, Vinsensius Rianto, Dicky Candra Nico, Dea Anita Ariani Kurniasih, Salsabila Salwa, Dinda Prisilya Diningrum, Ikechukwu Benjamin Moses, and Riza Zainuddin Ahmad. 2025. Antibiotic resistance profiles of Escherichia coli and Salmonella spp. isolated from chicken meat sold in traditional markets in Gresik District, East Java, Indonesia. Open Veterinary Journal, 15 (5), 2160-2170. doi:10.5455/OVJ.2025.v15.i5.34 Chicago Style Wibisono, Freshinta Jellia, Mustofa Helmi Effendi, Wiwiek Tyasningsih, Reina Puspita Rahmaniar, Aswin Rafif Khairullah, Irfan Alias Kendek, Budiastuti Budiastuti, Vinsensius Rianto, Dicky Candra Nico, Dea Anita Ariani Kurniasih, Salsabila Salwa, Dinda Prisilya Diningrum, Ikechukwu Benjamin Moses, and Riza Zainuddin Ahmad. "Antibiotic resistance profiles of Escherichia coli and Salmonella spp. isolated from chicken meat sold in traditional markets in Gresik District, East Java, Indonesia." Open Veterinary Journal 15 (2025), 2160-2170. doi:10.5455/OVJ.2025.v15.i5.34 MLA (The Modern Language Association) Style Wibisono, Freshinta Jellia, Mustofa Helmi Effendi, Wiwiek Tyasningsih, Reina Puspita Rahmaniar, Aswin Rafif Khairullah, Irfan Alias Kendek, Budiastuti Budiastuti, Vinsensius Rianto, Dicky Candra Nico, Dea Anita Ariani Kurniasih, Salsabila Salwa, Dinda Prisilya Diningrum, Ikechukwu Benjamin Moses, and Riza Zainuddin Ahmad. "Antibiotic resistance profiles of Escherichia coli and Salmonella spp. isolated from chicken meat sold in traditional markets in Gresik District, East Java, Indonesia." Open Veterinary Journal 15.5 (2025), 2160-2170. Print. doi:10.5455/OVJ.2025.v15.i5.34 APA (American Psychological Association) Style Wibisono, F. J., Effendi, . M. H., Tyasningsih, . W., Rahmaniar, . R. P., Khairullah, . A. R., Kendek, . I. A., Budiastuti, . B., Rianto, . V., Nico, . D. C., Kurniasih, . D. A. A., Salwa, . S., Diningrum, . D. P., Moses, . I. B. & Ahmad, . R. Z. (2025) Antibiotic resistance profiles of Escherichia coli and Salmonella spp. isolated from chicken meat sold in traditional markets in Gresik District, East Java, Indonesia. Open Veterinary Journal, 15 (5), 2160-2170. doi:10.5455/OVJ.2025.v15.i5.34 |